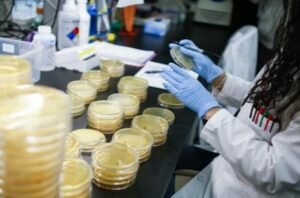

Coronavirus.- Andalucía suma 119 casos, menor alza desde el 16 de marzo, y las muertes repuntan con 21 fallecidos
Almería registra este martes solo un contagio y diez personas más curadas
Andalucía alcanza los 10.306 positivos por coronavirus tras sumar 119 en 24 horas, la menor subida en un día desde el pasado 16 de marzo, según los datos difundidos este martes por la Consejería de Salud y Familias, que señala que los fallecidos en la comunidad autónoma son 836, lo que supone 21 más de una jornada a otra con un ligero repunte de cinco muertes más que el lunes.
La cifra de contagios facilitada por la Consejería de Salud registra una diferencia de 114 nuevos pacientes positivos en relación a la publicada a las 11,30 horas de este martes por el Ministerio de Sanidad, que sólo registraba un aumento diario de cinco contagios en Andalucía. La Junta argumenta en un comunicado que esta diferencia obedece a que incluye en su recuento «como caso confirmado a las personas asintomáticas que han dado positivo a Covid-19».
Estos 119 nuevos positivos de este martes siguen la tendencia de crecimiento contenido de las últimas jornadas y suponen el menor aumento diario desde el 16 de marzo, cuando se registraron 117 nuevos casos en 24 horas. Por contra, la cifra de fallecidos registra un ligero repunte en 24 horas al pasar de los 16 del lunes a los 21 de este martes, aunque constituye el mejor dato diario de la última semana si se excluye la jornada de ayer.
Los datos acumulados son:
| Provincia | Positivo | Casos que han precisado hospitalización | Casos que han precisado ingreso UCI | Fallecimientos | Curados |
| Almería | 414 | 176 | 34 | 38 | 96 |
| Cádiz | 1.001 | 452 | 70 | 60 | 203 |
| Córdoba | 1.190 | 462 | 57 | 58 | 197 |
| Granada | 1.864 | 973 | 110 | 180 | 375 |
| Huelva | 337 | 177 | 27 | 27 | 61 |
| Jaén | 1.177 | 590 | 59 | 111 | 209 |
| Málaga | 2.240 | 1.253 | 145 | 184 | 597 |
| Sevilla | 2.083 | 971 | 129 | 178 | 294 |
| Total | 10.306 | 5.054 | 631 | 836 | 2.032 |
1.662 PACIENTES SIGUEN HOSPITALIZADOS, 358 EN LA UCI
Por su parte, la cifra de hospitalizados en Unidades de Cuidados Intensivos (UCI), que alcanza los 631, apenas 10 más en 24 horas tras sumar sólo dos personas el día anterior, lo que supone un mínimo repunte tras el menor crecimiento diario desde el inicio de la pandemia registrado este lunes. Actualmente, 1.662 pacientes confirmados con COVID-19 permanecen ingresados en los hospitales andaluces –seis más en 24 horas–, de los que 358 se encuentran en UCI –ocho más–, según la Consejería de Salud.
También persiste la tendencia al alza en la cifra de curados aunque se sigue ralentizando, con 65 más en 24 horas hasta alcanzar los 2.032. No obstante, el dato es prácticamente la mitad de los 129 más registrados el lunes.
Ello permite que Andalucía siga aumentando la diferencia de curados respecto al número de fallecidos (1.196) en la séptima jornada consecutiva en la que la cifra de nuevos curados supera a la de nuevos hospitalizados –61 más– en 24 horas. Además la cifra diaria de contagios cae por debajo de la de curados tras tres días seguidos superándola.
779 TEST RÁPIDOS ESTE LUNES
Además, la Junta subraya que la aplicación móvil de Salud Responde ha superado las 563.000 consultas desde el pasado 25 de febrero hasta la actualidad siendo el 27,2% para la realización de los test rápidos, llevándose a cabo 779 pruebas este lunes y más de 153.000 desde su puesta en marcha el sábado 14 de marzo, con el fin ayudar a las personas a determinar de forma inicial si necesitan o no asistencia sanitaria y facilitarles la toma de decisión.
Por último, recuerda que EPESha habilitado dentro de esta App de descarga gratuita un asistente virtual, que ha mantenido 35.465 conversaciones en con los usuarios para resolver dudas generales sobre el coronavirus. Este asistente virtual o chatbot pretende ser otra vía de información a la ciudadanía sobre el coronavirus, con la que mejorar el servicio al ciudadano y está disponible también a través de la página web de la Empresa Pública de Emergencias Sanitarias (www.epes.es) y la red social Telegram (Asistentes Virtual Coronavirus Andalucía).
Consultas sobre coronavirus
La Empresa Pública de Emergencias Sanitarias (EPES) ha registrado desde el inicio del estado de alarma hasta el 13 de abril un total de 4.272.382 llamadas por todas las líneas, recibiendo 157.223 en el día de ayer. De ellas, los 8 Centros Coordinadores de Urgencias y Emergencias Sanitarias pertenecientes al 061 en Andalucía gestionaron el 7,7% de llamadas, el 90,7% fueron atendidas desde el 955 545 060 de Salud Responde y a través del 900 400 061, habilitado para la atención exclusiva de las consultas sobre coronavirus, se han recibido el 1,6% restante. Esta línea ha registrado desde su puesta en funcionamiento 245.260 llamadas.
Las primeras consultas por coronavirus comenzaron a ser solventadas por los centros de la Empresa Pública de Emergencias Sanitarias el pasado 25 de febrero. Desde esa fecha hasta el día ayer, los centros coordinadores de 061 y Salud Responde han resuelto 157.746 peticiones de asistencia o de información por este motivo. En la jornada de ayer, los centros del 061 gestionaron 590 de ellas (siendo el 87% solicitudes de asistencia) y en Salud Responde se atendieron 720 consultas, (70% informativas y el 30% asistenciales).
La aplicación móvil de Salud Responde ha superado las 563.000 consultas desde el pasado 25 de febrero hasta la actualidad siendo el 27,2% para la realización de los test rápidos, llevándose a cabo 779 pruebas en el día de ayer y más de 153.000 desde su puesta en marcha el sábado 14 de marzo, con el fin ayudar a las personas a determinar de forma inicial si necesitan o no asistencia sanitaria y facilitarles la toma de decisión.
La Empresa Pública de Emergencias Sanitarias ha habilitado dentro de esta App de descarga gratuita un asistente virtual, que ha mantenido 35.465 conversaciones en con los usuarios para resolver dudas generales sobre el Coronavirus. Este asistente virtual o chatbot pretende ser otra vía de información a la ciudadanía sobre el coronavirus, con la que mejorar el servicio al ciudadano y está disponible también a través de la página web de la Empresa Pública de Emergencias Sanitarias (www.epes.es) y la red social Telegram (Asistentes Virtual Coronavirus Andalucía).
Agradecimientos
Como cada día, la Consejería de Salud y Familias quiere expresar su agradecimiento a la magnífica labor que vienen realizando todos los profesionales de los centros sanitarios andaluces en estas circunstancias excepcionales, demostrando una vez más su responsabilidad, compromiso e implicación en la lucha contra esta epidemia. De igual modo, hace extensible dicha felicitación a los profesionales de la Unidad Militar de Emergencias (UME) y al personal del INFOCA, que se incorpora en las labores de limpieza y logística. También al personal de las residencias de mayores que, desde un primer momento, ha mostrado su total colaboración y que realizan una labor extraordinaria, así como al personal de ayuda a domicilio que vela continuamente por el bienestar de las personas más vulnerables.
La Consejería de Salud y Familias también quiere agradecer el ofrecimiento altruista de empresas Tecnológicas, Fundaciones, Restauración a domicilio, Hostelería, Colegios profesionales, Organizaciones sindicales y patronales, taxistas, entre muchas otras, para apoyar las necesidades de la población derivadas de la epidemia de Coronavirus.
Puedes seguir las respuestas de esta entrada por el RSS 2.0. Puedes ir al final y dejar una respuesta. Pinging no esta permitido







EL RINCÓN DE LA SIRENITA
LA VENTANA DE LA FE
SUCESOS
EN CLAVE DE HUMOR
DOCUMENTOS